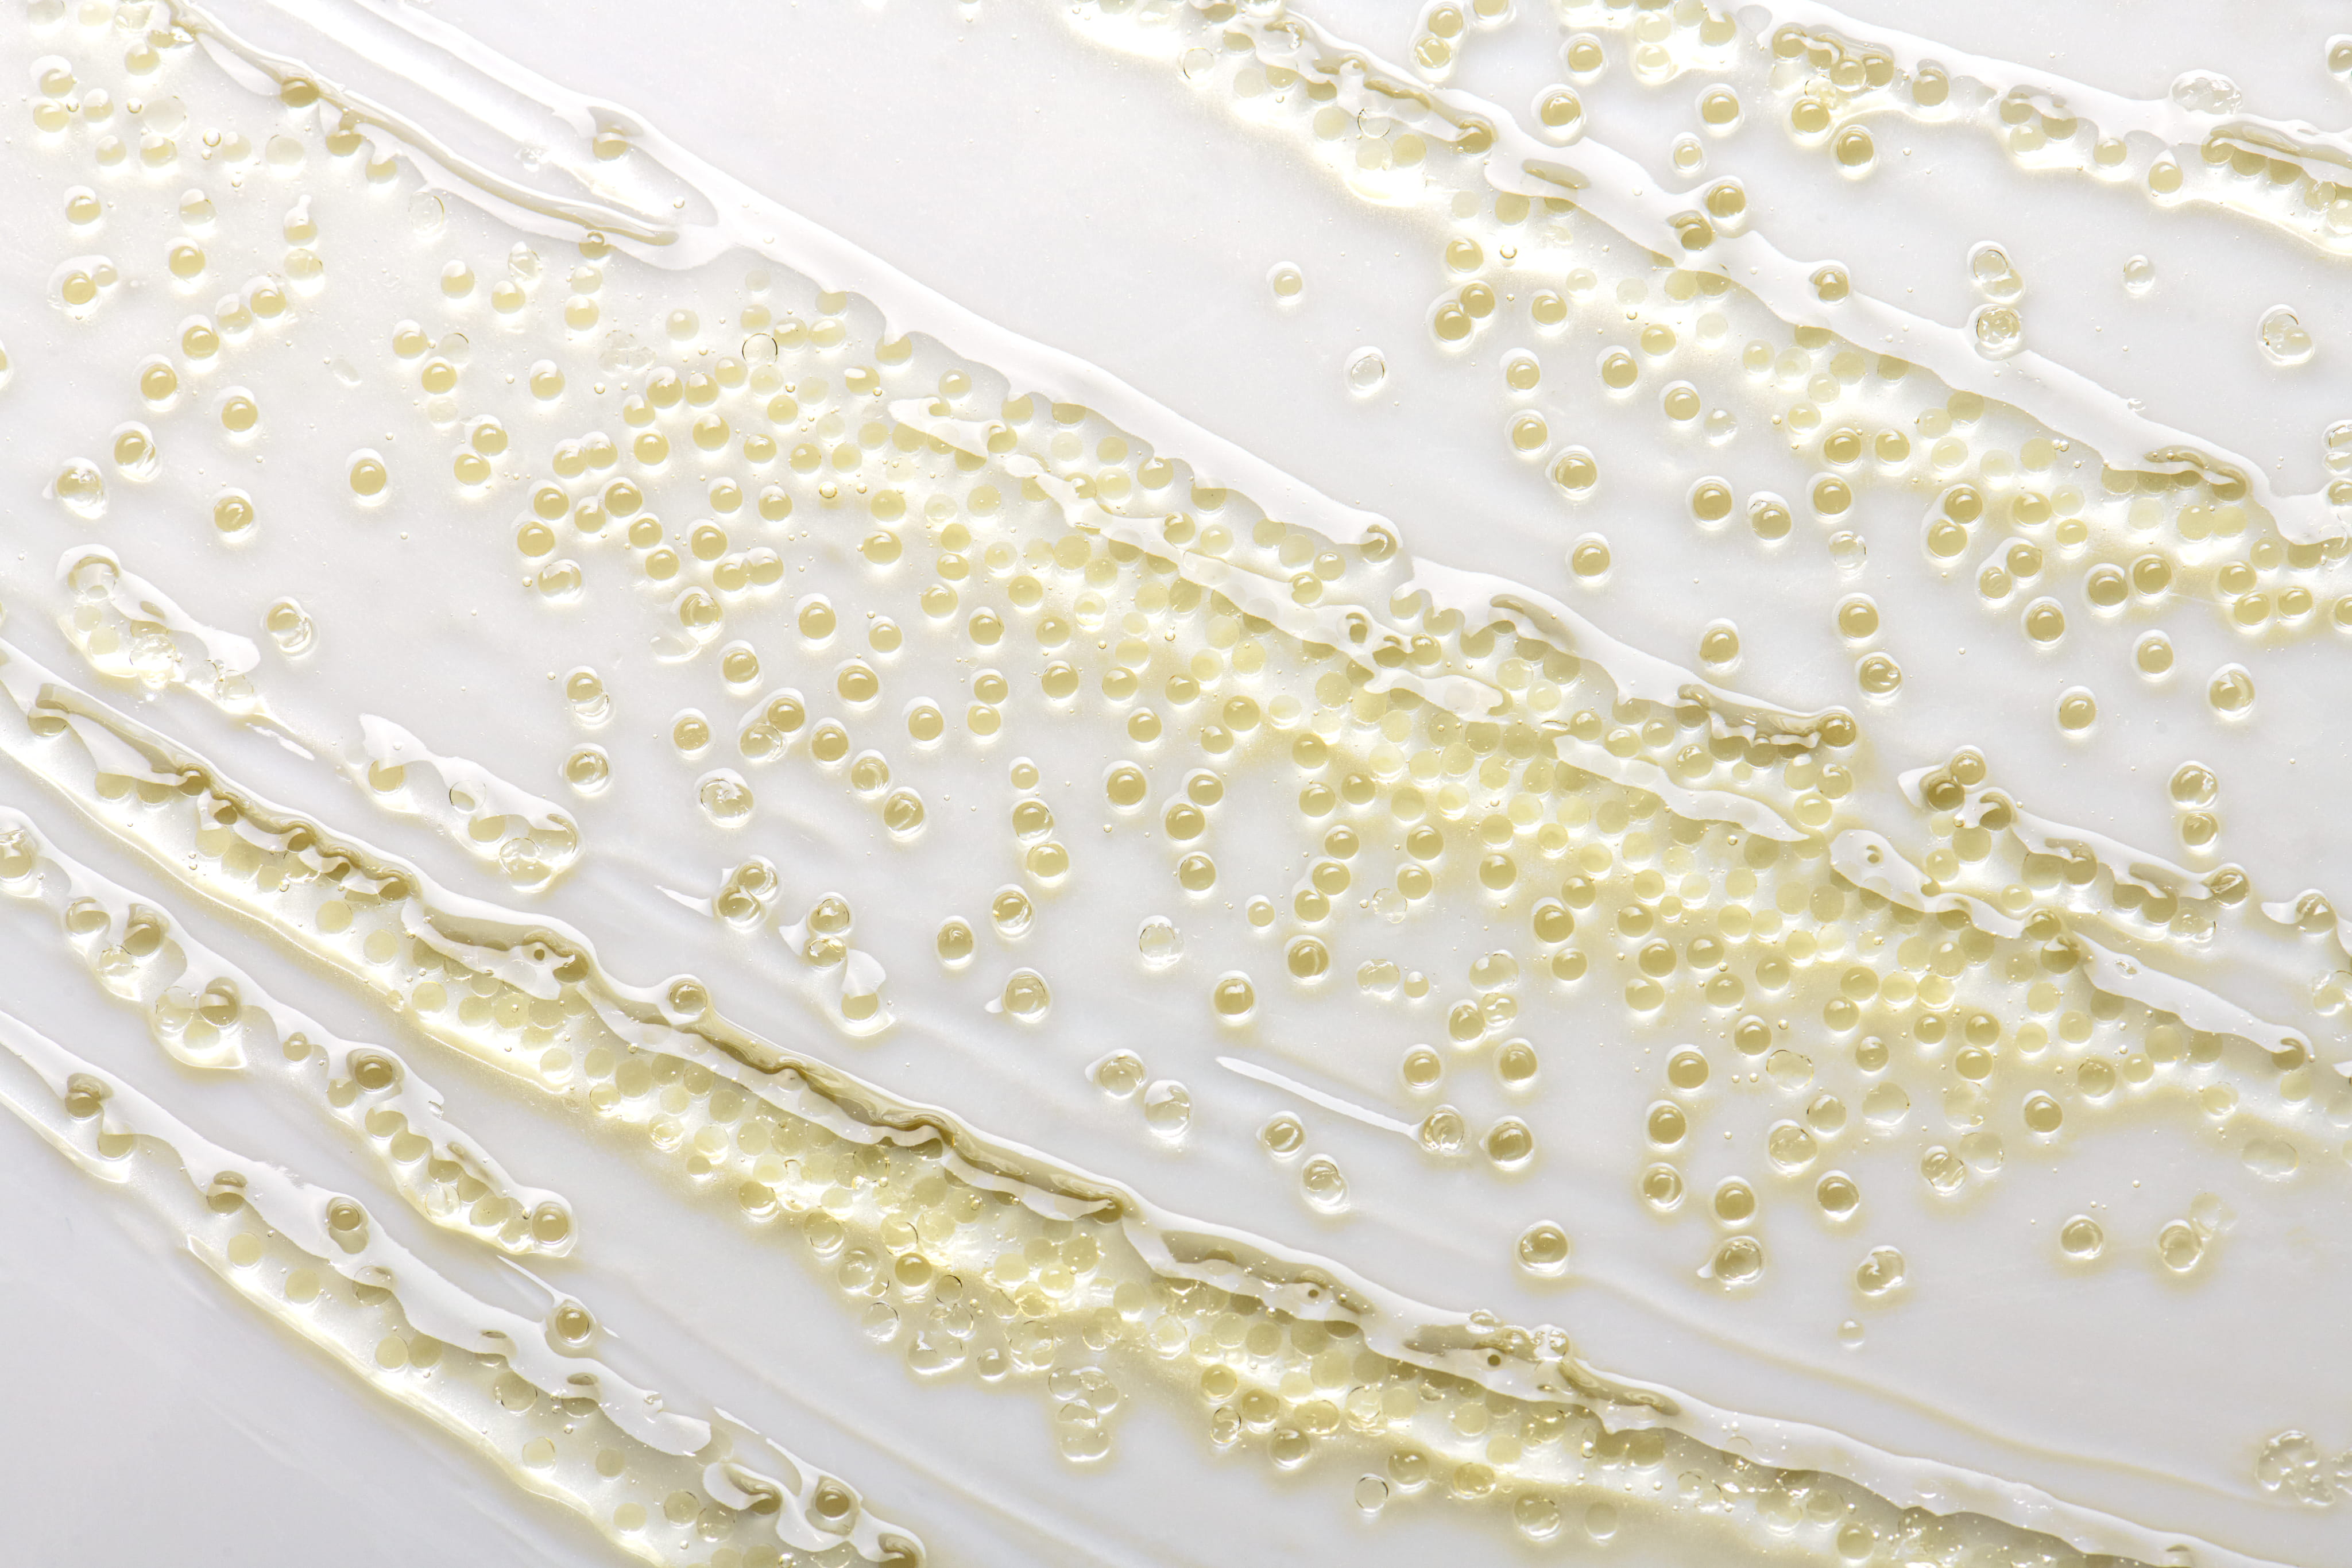

Éclat Sublime Dual Rejuvenating Micro-Serum
Un siero liquido bifasico che ripara, rivitalizza e rassoda la pelle per un incarnato più radioso.
Un siero ad alte prestazioni che combina l'efficacia e la leggerezza di un siero con il comfort di lussuosi oli ad alto potenziale. Un'esperienza lussuosa per la tua pelle grazie al perfetto equilibrio tra una formula a base di acqua e oli incapsulati.
Formulato con il complesso Pepti-Botanico ringiovanente avanzato e un Duo di Bio-Ottimizzatori, rafforza e ricostruisce la pelle dall'interno. Questo siero a doppia fase rafforza la barriera protettiva della pelle e favorisce la produzione di collagene per una pelle dall'aspetto più giovane. Il 95% degli ingredienti sono di origine naturale.*
*Nel rispetto dello standard ISO 16128, ingredienti derivati da piante, non da derivati del petrolio, minerali.
Ideale per
- Tutti i tipi di pelle
- Barriera cutanea stressata / indebolita
- Segni del tempo e rughe
- Opacità della pelle
Risultati comprovati
*Clinicamente testato su 29 donne, 4 ore dopo l'applicazione
Ingredienti chiave
*Secondo lo standard ISO 16128, da fonti vegetali, minerali non petrolati e/o acqua

RINFORZA • LEVIGA • ILLUMINA
Doppio siero
Doppia texture
Doppi risultati
2XRÉDUCTION DES RIDES1
2XPEAU PLUS FERME1
+36%BARRIÈRE CUTANÉE PLUS FORTE2
1Confronto della percentuale di miglioramento dopo 8 ettimane di utilizzo del prodotto rispetto alla condizione iniziale, rispetto alla percentuale di miglioramento dopo 1 settimana rispetto alla condizione iniziale, su 38 donne, applicazione due volte al giorno.
2Test clinico condotto su 26 donne dopo una singola applicazione del prodotto.

RINFORZA • LEVIGA • ILLUMINA
Doppio siero
Doppia texture
Doppi risultati
2XRÉDUCTION DES RIDES1
2XPEAU PLUS FERME1
+36%BARRIÈRE CUTANÉE PLUS FORTE2
1Confronto della percentuale di miglioramento dopo 8 ettimane di utilizzo del prodotto rispetto alla condizione iniziale, rispetto alla percentuale di miglioramento dopo 1 settimana rispetto alla condizione iniziale, su 38 donne, applicazione due volte al giorno.
2Test clinico condotto su 26 donne dopo una singola applicazione del prodotto.

Competenza formulativa
La Scienza della Cera-Glicazione
Inspiré par la science des glyco-céramides, leMicro-Sérum Éclat Sublime agit à la fois sur la prévention de la glycation et la restauration des céramides. Due meccanismi biologici chiave dell’invecchiamento vengono così affrontati simultaneamente.

Competenza formulativa
La Science de la Cera-Glycation
Inspiré par la science des glyco-céramides, le Micro-Sérum Éclat Sublime agit à la fois sur la prévention de la glycation et la restauration des céramides. Due meccanismi biologici chiave dell’invecchiamento vengono così affrontati simultaneamente.

Texture
UNE TEXTURE BI-PHASE
POUR UN DOUBLE RESULTATS
La texture bifasica raggiunge il perfetto equilibrio tra leggerezza e nutrimento.
Al momento dell’applicazione, la fase in gel rinfrescante si fonde armoniosamente con gli oli avvolgenti,
rilasciando un’idratazione profonda e reintegrando i lipidi.
La pelle appare immediatamente morbida e rimpolpata.
Texture
UNE TEXTURE BI-PHASE POUR UN DOUBLE RESULTATS
La texture bifasica raggiunge il perfetto equilibrio tra leggerezza e nutrimento. À l’application, la phase gélifiée rafraîchissante fusionne harmonieusement avec les huiles réconfortantes, libérant une hydratation profonde et reconstituant les lipides. La pelle appare immediatamente morbida e rimpolpata.










































